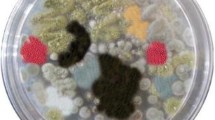

Abstract
Synthetic coloring agents have been broadly utilized in several industries such as food, pharmaceuticals, cosmetic and textile. Recent surveys on the potential of teratogenicity and carcinogenicity of synthetic dyes have expressed concerns regarding their use in foods. Worldwide, food industries have need for safe, natural and new colorings to add variety to foods and make them appealing to consumers. Natural colorings not only expand the marketability of the food product, but also add further healthful features such as antibacterial, antioxidant, anticancer and antiviral properties. Novel microbial strains should be explored to meet the increasing global search of natural pigments and suitable techniques must be developed for the marketable production of new pigments, using microbial cultures, viz., fungi, and bacteria. To address the issue of the natural coloring agents, this review presents the recent trends in several studies of microbial pigments, their biological properties and industrial applications.
Similar content being viewed by others
Avoid common mistakes on your manuscript.
Introduction
About 3000 components in the food additive database of the Food and Drug Administration (FDA) have been listed and recent studies testify that at present there are almost 2500 kinds of food additives generally utilized in food products [1]. The current global use of pigments is nearly 9.7 million tons [2]. In 2014, approximately 45% of the overall pigment application was associated with the paint and textile industries, while the remaining part was in food/feed and pharmacy applications [3]. Moreover, as mentioned by Venil et al. [4], textile industry, which utilizes huge amounts of chemical dyes, needs more quantities of biopigments and this issue has led to industrializing the production of eco-friendly and safe microbial colorants. Concerns about the quality and safety of industrialized food products, which contain artificial colorings, are the main reason for the scientist's attention toward non‐toxic and naturally derived pigment alternatives [5, 6]. The significance of synthetic colorants is because the appearance of food products affects consumer’s preference. Thus, the necessity of artificial pigments cannot be overseen if the customer’s tendency is to be satisfied [6, 7].
Microbial pigments are quickly replacing synthetic colorings (some of them may have teratogenic and carcinogenic properties), since they are eco-friendly and nontoxic to humans for application as food additives [2, 8]. This trend is not only limited to microbial pigments as coloring agents. For instance, microbial pigments with antioxidant activities, such as saproxanthin and zeaxanthin, are preferred to synthetic antioxidants like butylated hydroxyl acids (BHA) and butylated hydroxyl toluene (BHT) [9]. In addition, microbial pigments not only increase the color of foods, but also offer populous medicinal advantages such as anticancer, antioxidant, antimicrobial, immunosuppressive, anti-inflammatory, and antiproliferative activities [10,11,12]. Figure 1 illustrates some of the biopigments that are generally recognized as safe (GRAS) and produced by microbial strains.
Biopigments are produced by the various kinds of microorganisms such as Serratia, Streptomyces, Monascus, Penicillium mallochii, Paecilomyces, and Cordyceps [13,14,15,16,17,18,19]. Biopigments are being scrutinized particularly as a free available source of coloring agents to substitute synthetic chemical pigments. Moreover, the developing market of the natural food colorings for maintaining consumer's interest depends on biopigments’ enhancement [19, 20]. A variety of biopigments are present in global trade, while the most traditional ones include fungal Monascus pigments, astaxanthin (from Paracoccus carotinifaciens), Arpink red™ (from Penicillium oxalicum), riboflavin (from fungus Ashbya gossypii), lycopene and β-carotene (from Blakeslea trispora and Dunaliella salina) and microalgal phytocyanin (from Arthrospira platensis) [21]. Recent studies on biopigment production by different microbial species and cultural conditions are mentioned in Table 1.
By this time, the arguments against the application of artificial coloring agents in many countries have prohibited the consumption of several synthetic colorants such as Blue FCF, Blue No.1 and No.2. Alternatively, at the present time, natural pigments are going to be more utilized rather than chemically synthesized ones [22]. Industrial-scale production of biopigments is the other notable point. The microbial pigments provide other advantages such as low-cost production method, higher yield and economic extraction systems. Besides, the production of microbial pigments can be more improved by the optimization of growth conditions [23]. Different parameters are effective in optimization of microbial pigment production, such as the type of nitrogen and carbon source (nutrient medium composition), bioreactor type and culture conditions (aeration, agitation, temperature and pH). Thus, several recent investigations have focused on studying these parameters to achieve the proper growth requirements of the pigment-producing microorganisms [24].
Former investigations revealed that industrial production of microbial pigments continues to be in the exploration and developmental stage. This literature review explains the current situation of microbial pigments as food colorings/additives and emphasizes the significance of the novel pigment secreting microbial strains, studying health-aiding effects, industrial-scale production and exploring the systems with high-yield extraction.
Biosynthesis of microbial pigments
To upscale the production of biopigments, there is a necessity for the advancement of low-priced procedures for the extraction of microbial pigments [25]. Studying biomechanisms involved in the creation of pigmented molecules is a key factor in the optimization of industrial-scale production. Figure 2 shows a schematic diagram of the extraction and purification procedure of microbial pigments.
As mentioned by Nawaz et al. [22], several studies have suggested various biological pathways of pigment production by microbial strains and biochemical enzymatic transitions. Nonetheless, until now it is not accepted that the enzymatic or biological pathways are similar or distinct for different pigment-producing microbes [22]. Due to the high cost of synthetic growth media, the utilization of agro-industrial wastes would be the solution for reducing the cost [26]. Some general techniques that are used in color extraction from culture media include sonication-assisted extraction, high hydrostatic pressure extraction (HHP), enzymatic extraction, pulse electric field extraction (PEF), gamma irradiation-assisted extraction and membrane technology [27]. Herein, we have described a number of common biosynthesis techniques.
Fermentation
As mentioned by Pombeiro-Sponchiado et al. [28], the factors affecting pigment production in fermentation technology are nitrogen and carbon concentration, presence of oxygen, medium pH, light, and the components of culture medium. In this regard, Liu et al. [29] studied the application of rice straw hydrolysate as a substrate in submerged fermentation for the production of Monascus pigments (MPs) by Monascus purpureus M630. MPs are secondary metabolites generated by the fungal strains of Monascus spp., which are a part of important coloring agents in food, textile, and cosmetic industries. The results indicated that M. purpureus M630 makes 8.61 U mL−1 and 20.86 U mL−1 of extracellular MPs in rice straw hydrolysate alone or in combination with glucose fermentation medium, respectively. Further analysis revealed that metabolites produced during the hydrolysis of rice straw (including furfural and 5′-hydroxymethyl furfural) has inhibitory effect on microbial growth and fermentation, while the M. purpureus M630 improves adaptation mechanisms in response to these metabolites. This study validates that submerged fermentation of rice straw hydrolysate by Monascus spp. can provide a low-cost method for the production of the MPs [29].
In another study, Loh et al. [30] investigated the ability of Gordonia terrae TWRH01, a marine bacterium isolated from seawater of northern Taiwan, in the production of carotenoids. The biochemical characteristics of the G. terrae TWRH01 were analyzed by application of different fermentation strategies. According to the results, G. terrae TWRH01 can professionally produce carotenoids in cultures adjusted to pH 7 and containing 16 g L−1 yeast extract as the nitrogen source and 16 g L−1 sucrose as the carbon source. Moreover, the optimization of fermentation process yielded 10.58 μmol L−1 relative β-carotene concentration and 15.29 g.L−1 dry biomass; however GC–MS analysis showed that the produced pigments were echinenone and adonixanthin 3′-β-d-glucoside, which are the main carotenoid derivatives. This novel bacterial strain can serve as a bioresource of the commercial natural carotenoids [30].
Genetic engineering
Wild strains of pigment-secreting microbes generate low quantities of the biopigments, which cannot be used for industrial-scale production. Therefore, these strains should be manipulated for enhancement of pigment generation capacity. Strain improvement is supposed to genetic mutation and/or other metabolic engineering tools to reform microbe characteristics to preferred biochemical pathways that are responsible for the increase of biopigment synthesis [31]. Recent studies indicated that use of mutagens such as ethyl methane sulfonate (EMS), ultraviolet (UV), 1-methyl-3- nitro-1-nitrosoguanidine (NTG) and microwaves can lead to several fold improvement of pigment generation [32]. For this purpose, the genetic material of the microorganisms could be reorganized by genetic engineering, which includes genetic mutations and/or recombinant DNA technology. In this technology, the genetic structure of a microorganism changes in a mode to amplify the yield of pigments [33].
By this way, Liu et al. [34] explored biotechnologically produced Monascus azaphilone pigments (MonAzPs), which were generated by an engineered M. purpureus HJ11. Exogenous cyclic adenosine monophosphate (cAMP) treatment intensified the MonAzPs production and increased the expression of cAMP phosphodiesterase gene, known as mrPDE, in M. purpureus HJ11. The results indicated that ΔmrPDE strain generated MonAzPs at 8563 U g−1, with a 2.3-fold growth in comparison with the primary strain. Besides, the biochemical characteristics of the engineered strain showed that NAPDH/NADP+ ratio of the ΔmrPDE strain was noticeably higher than that of the wild strain, which led to a higher percentage of MonAzPs. In addition, it should be noted that, through fed-batch fermentation of the ΔmrPDE strain, the final yield of yellow MonAzPs achieved 8739 U.g−1. This study presents a roadmap for genetic engineering surveys headed for the production of biopigments by other fungal strains [34].
Recently, Song et al. [35] conducted a study on exploring the gene engineering of a Chlamydomonas strain for zeaxanthin production. Zeaxanthin is a type of biopigment that assists the body in avoiding age-related macular degeneration. In this study, a double knockout mutant was created by the CRISPR-Cas9 ribonucleoprotein-mediated knock-in system and then lycopene epsilon cyclase (LCYE) was modified for the removal of the α-branch of xanthophyll biosynthesis in a knockout mutant of the zeaxanthin epoxidase gene (ZEP). Results signified that, after 3 days of cultivation, the double knockout mutant had zeaxanthin yield 5.24 mg L−1 and zeaxanthin content 7.28 mg g−1, which was about 60% higher than that of parental cell lines. This work indicated that the difficulties of the downstream process for the fabrication of high-purity zeaxanthin can be solved by genetic engineering [35].
Agro-industrial waste
The accumulation of food waste can lead to significant global concerns such as economic, environmental and social issues. On the other hand, these by-products are a highly valued source of important antioxidant compounds such as polyphenols that should be extracted for industrial applications through biotechnological approaches. Therefore, the management of industrial food by products is necessary for the removal of accumulated food waste, and to reprocess these rich by-products to increase the economic value [36].
According to Kalra et al. [18], Nevzglyadova et al. [37] and Fernandes et al. [38], filamentous fungi and yeasts are a valuable source of numerous pigments such as phenazines, melanins, quinones, and flavins. The yeast groups that can synthesize carotenoid pigments include species of the genera Rhodotorula, Rhodosporidium, Sporidiobolus, Sporobolomyces and Phaffia rhodozyma (also its teleomorph Xanthophyllomyces dendrorhous) [39]. A new pigment being studied is the red pigment generated by Saccharomyces cerevisiae mutants, which is a result of polymerization of 1-(5′-phosphoribosyl)-5-aminoimidazole containing amino acid residues and is characterized by a molecular weight from 2 to 10 kDa [40]. The biosynthesis of pigment in fungal cells initiates with the conversion of acetyl-CoA, which is created in the β-oxidation of fatty acids. In mevalonic acid pathway, different biochemical reactions are catalyzed by specific decarboxylases, kinases, and reductases to generate isopentenyl pyrophosphate (IPP) that is a 5-carbon carotenoid precursor and the addition reactions of three IPPs lead to the formation of geranyl–geranyl pyrophosphate (GGPP), with 20 carbon atoms per molecule. Finally, the compression of the two GGPP produces phytoene (C40) which is a precursor to biosynthesis of lycopene. Next, the produced lycopene can be transformed into lutein, γ-carotene, β-carotene, torulene, torularhodin, astaxanthin, and zeaxanthin depending on the type of microorganisms [41].
In this context, Lobo et al. [42] studied the carotenoid fabrication by pigmented yeasts Rhodotorula mucilaginosa, isolated from Bahia’s semi-arid region, employing sugarcane juice as a substitute of fermentation culture medium. Yeast extract, pH, sugarcane juice and stirring speed were explored as the independent variables affecting yeast cell growth and pigment production. The results showed that the maximum production of carotenoid was 1300 μg L−1 which was obtained in 6 g L−1 yeast extract, initial pH of 6.8, 40% sugarcane juice, and stirring speed of 176 RPM. This study revealed that controlling the environmental conditions (including pH and stirring speed) in sugarcane culture supplemented with yeast extract could advance the bioproduction of carotenoids and biomass [42].
Industrial applications and pharmacological activities
Legislation of biopigments
Similar to all confirmed food additives, the microbial pigments are subject to accurate regulation and approval procedure before the application in food industry. In addition, biopigment purification technique must not let the entrance of any allergic and/or toxic metabolite into the main product [43]. A number of synthetic food colorants legislated by FDA include mono- and di-azo dyes that are the most general food-grade colorings, quinophthalones, xanthene dyes, and triarylmethane derivatives [44]. Mineral pigments such as titanium dioxide (E171), iron oxides (E172) and calcium carbonate (E170) [43] are also approved as food colorants. As mentioned by Nigam et al. [45], 43 colorings are accepted as food additives in European Union, while around 30 colorants are permitted in the USA and 6 colorings of these 30 additives are of microbial pigments which are listed in Table 2.
Pigment purification
Cost-effective separation techniques are significant factors for industrial production of microbial pigments because commercial recovery of biopigments with conventional procedures is highly priced. Purification of microbial pigments can be carried out by conventional techniques such as differential extraction, countercurrent extraction, differential crystallization and adsorption column chromatography [32]. Moreover, extraction of pigments by organic solvents is a time-consuming and problematic method due to the considerable quantities of exhausted solvents and even low purity of the final product. The most generally used solvents are chloroform, hexane, acetone, cyclohexane, dichloromethane, methanol, isopropanol, ethanol, benzene, diethyl ether, carbon disulfide, and supercritical carbon dioxide, which have been diffused in latest investigations [46]. On the other hand, as most of the organic solvents are not natural, the utilizing of solvents other than ethanol and water can cause failure to the aim of obtaining a microbial pigment for monitoring purposes. Also, the use of non-ionic adsorption resins for an effective purification has been employed to many biomolecules such as organic acids, nucleic acids, and peptides [47]. These resins have an excessive loading capacity, and thus can be useful in recovering biopigments in large scales, and they can directly be utilized to adsorb different substances from the culture broth. The cost of purification is lowered in this technique by decreasing the exhausted solvents and increasing its reusability [32].
In this regard, Zhu et al. [48] separated a novel blue pigment from Streptomyces sp. A1013Y. The purified natural pigment was recognized as 4,8,13-trihydroxy-6,11-dione-trihydrogranaticins A (TDTA) with a molecular weight of 462 Da and solubility in organic solvents. For TDTA purification, 10 L of the fermentation broth was concentrated by evaporation to a volume of 1 L. The concentrate was eight times extracted with ethyl acetate (EtOAc) and the final combined extracts were evaporated to 150 ml under reduced pressure. Then the remaining extract was passed over a silica gel column and the concentrated fractions were monitored by thin layer chromatography (TLC). Finally, the pure blue TDTA pigment powder from HPLC purification was gained for further identification. The color of TDTA was relatively stable from pH 3 to pH 11, between 20 and 100 °C, and under UV light. TDTA exhibited excellent free radical scavenging properties, IC50 13.75 µg/mL and 41.04 µg/mL using 2,2-n-(3, 2-ethyl-benzothiazole-6-sulfonic acid) ammonium salt (ABTS) and 2, 20-diphenyl-1-picrylhydrazyl (DPPH), respectively. TDTA might be a promising source of bioactive compound used as food additive [48].
Industrial applications
Food colorants
As synthetic color additives have exhibited negative health effects following their consumption, the food manufacturers are turning to natural food colorants and this need should be met by the industrial production of biopigments [49]. Food and pharmacological products containing microbial pigments are presented in Fig. 3. Among different sources of natural colorings, microbial pigments act as important food colorings due to the easy generation and downstream procedure. Microbial fermentation is the most employed technique in pigment production, since it offers numerous advantages such as greater yield, inexpensive production, uncomplicated strain improvement, easier extraction, and no seasonal changes [50]. According to Dufossé [51], the success of an industrially produced pigment by fermentation or other techniques depends on its approval by national regulatory agencies like FDA/WHO, acceptability in the market and the initial investment for bringing the product to market. On the other hand, technical limitations are the main barrier for the industrial utilization of the source ingredients.
In contrast, some pigments such as pyocyanins are not of food grade, while they exhibit antioxidant and antimicrobial activity. Pyocyanin is a blue-colored pigment that is found in Pseudomonas sp. In this regard, Saleem et al. [52] have characterized pyocyanin extracted from chromogenic Pseudomonas species for its antioxidant potential. They studied Pseudomonas aeruginosa DSM 50,071, which was isolated from aquatic environments of Pakistan and identified by 16S rRNA gene sequencing for production of pyocyanin. P. aeruginosa is a Gram-negative, facultative, aerobic, rod-shaped and opportunistic bacterium that produce different redox-active phenazine pigments including pyocyanin. The results indicated that pyocyanin at concentration of 50 μg ml−1 has 52.5% free radical scavenging of ABTS compared to BHA (86.0%) and Trolox (67.4%) and 58.0% inhibition of DPPH in comparison to BHT (88.1%) and Trolox (68.5%). Additionally, the pyocyanin at concentration of 50 μg ml−1 exhibited antibacterial and antifungal activity against foodborne pathogens such as Staphylococcus aureus, Staphylococcus enterica, Escherichia coli, Fusarium oxysporum and Aspergillus niger [52].
In another survey conducted by Ramesh et al. [53], the diversity and bioprospecting aspects of pigments extracted from marine bacterial strains were studied. Approximately, 180 samples were collected and the results revealed that orange- and red-pigmented bacterial stains were most abundant populations; from these strains 14 isolates were selected due to their intense pigmentation, and the pigments were tested for food colorant applications and bioactive nature. Two red-pigmented strains (BSE6.1 and S2.1) presented antioxidant potential, antibacterial activity and food colorant properties, and the chemical analysis (by HPLC, TLC and GC–MS) pointed out that prodigiosin was the main chemical component of pigments. Antibacterial tests proved that BSE6.1 requires 400 µg and S2.1 needs 300 µg and 150 µg of the red pigment for complete inhibition of S. aureus subsp. aureus. According to 16S rRNA sequence analysis, the strains BSE6.1 and S2.1 were identified as Streptomyces sp. and Zooshikella sp., respectively [53].
Cosmetics
The cosmetic industry has a vast global market and approximately 2000 cosmetic manufacturers are present just inside the USA [54]. Due to the application of different colorings in cosmetics and its worldwide market, efforts have focused on investigating the application of biopigments in cosmetics, especially skincare products [54]. In this regard, Srinivasan et al. [55] have reported the utilization of natural melanin pigment extracted from Streptomyces bellus MSA1 in the production of a bio lip ointment with the combination of lanolin, coconut oil and beeswax. Recent studies suggested the use of melanin pigment as an important element of several sunscreens, beauty care products, plastic films and varnishes, since melanin pigments can disperse above 99% of absorbed UV light [56].
In a recent investigation, Choksi et al. [57] have studied 19 pigment-producing bacterial strains, which were isolated from water and soil samples in India. Pigments produced by the 17 isolates presented sunscreen activity at a concentration 0.4–8.34 µg.mL−1 and six of them exhibited prominent antibacterial activity. However, the biopigments produced by Staphylococcus xylosus, which has been recognized by the 16S rRNA gene-sequencing method, were reported to be stable for up to five transfers and showed the most antibacterial and antioxidant activity with sun-protecting activity that could be used as an important ingredient in cosmeceuticals [57].
Pharmacological activities
Microbial pigments are appreciated for a variety of pharmacologically and biologically active compounds that exhibit anticancer, antibiotic, antioxidant, immunosuppressive and antiproliferative properties; thus, they can be a dominant substitute for synthetic constituents in the development of new drugs for treatment of pathological disorders. Efforts for investigating the biopigments produced by microbial strains are quickly growing as well as the number of isolated compounds in comparison to previous sources [58]. A number of recent studies on biopigments and their pharmacological functions are listed in Table 3.
Antioxidant activity
Recently, Keekan et al. [59] have studied the production of red pigment and its antioxidant activity by Talaromyces purpureogenus KKP isolated from soil. The central composite design (CCD) was used for optimization of cultural parameters including temperature, pH, peptone and dextrose concentrations. The results revealed that 6-hydroxymethyl-7, delphinidin, 8-dihydropterin, limonene, D-mannose-6-phosphate and CDP-DG (18:0/18:0) were the main elements of the produced pigments. The radical scavenging capacity of the extracted red pigment was determined through DPPH and ABTS assays. The DPPH scavenging rate ranged from 10 to 90% with half inhibition concentration (IC50) value of 40 µg mL−1 and the standard ascorbic acid showed IC50 value of 7.25 µg mL−1. In ABTS test, the IC50 of red pigment was 35 µg mL−1, while ascorbic acid was 7 µg mL−1 [59].
Anticancer and antiproliferative activity
Zeng et al. [60] explored the antioxidant and anticancer capacity of raw and fermented coix seed, by M. purpureus, using free radical scavenging assays and human laryngeal carcinoma cell HEp2, respectively. After fermentation, the coixenolide, tocols, and γ-oryzanol contents increased approximately 2, 4, and 25 times, respectively, compared to the raw seed. The extracted pigment produced by M. purpureus exhibited higher antioxidant activity in scavenging free radicals and inhibiting lipid oxidation. The anticancer activity of the extract was assessed by using the HEp2 cell line of human laryngeal carcinoma which accounts for 25% of head and neck cancers [61]. The IC50 of lipophilic extract from fermented seeds for inhibiting HEp2 cell lines decreased about 42%. This study revealed that fermentation by pigment-producing M. purpureus improved the anticancer activity of the extract, while its cytotoxicity against the normal CV-1 cells was low at the concentration of 10 mg mL−1, just 30.5% of the cells were inhibited. This study established that fermentation of coix seeds by M. purpureus could improve the anticancer activity [60].
In another study, Alem et al. [62] investigated the production and health benefits of the purple pigment, which is known as violacein and is secreted by an Antarctic bacterial isolate. Many studies have reported the antiproliferative activity of violacein in many cell lines. The results of survival assays revealed that the natural violacein has antiproliferative activity and sensitized cervix carcinoma cells (HeLa) to cisplatin. In addition, micronucleus assays showed violacein has no genotoxic activity in HeLa cells. This study confirmed that violacein is a robust biopigment which exhibits antiproliferative and/or anticancer activity for treatment of cervical cancer [62].
Antifungal activity
In this regard, Dawoud et al. [63] have conducted a study on the antifungal and antibacterial activity of yellow pigment produced by 20 different strains of endolichenic Bacillus sp. isolated from the lichen Dirinaria aegialita. The highest pigment yield was obtained in Luria–Bertani medium by a strain that was recognized as Bacillus gibsonii based on 16S rRNA genome sequence with 99% similarity. Based on ABTS assay, the SC50 of the pigment has been reported to be 75.125 ± 0.18 µg mL−1. Simultaneously, the antifungal activity of the pigment was assessed against different fungal species, viz., Fusarium oxysporum, Rhodotorula solani and Sterptomyces rolfsi. Moreover, terbinafine hydrochloride (1 mg mL−1) and methanol (100 µL) were exploited as positive and negative controls, respectively. The results of antifungal test pointed out that this pigment inhibits R. solani and S. rolfsi; however, mycelia lysis and length reduction were reported. On the contrary, no antibacterial activity has been reported [63].
Antibacterial activity
Pachaiyappan et al. [64] investigated the biological characteristics of carotenoids extracted from marine endophytic bacteria isolated from the bivalve, Donax cuneatus. Three new bacterial strains were identified using difference in 16S rRNA gene sequence including YP1, OP2 and PYP3. By chromatography, the purified pigment was recognized as astaxanthin, which offers cytotoxic effect on MCF-7 cell lines. The antibacterial potential of the pigments was tested against the pathogens such as S. aureus, E. coli, P. aeruginosa, Bacillus subtilis and Klebsiella pneumoniae, by measuring zone of inhibition in disc diffusion method. According to the results, PYP3 and OP2 strains exhibited greater inhibition zone. The violet pigment extracted from OP2 strain, which was identified as Chromobacterium violaceum, presented effective antibacterial activity against B. cereus, S. aureus, E. coli and P. aeruginosa. This violet pigment presented an 18 mm and 17 mm inhibition zone toward S. aureus and K. pneumoniae, respectively, which were the greatest values [64].
Antiviral activity
Suryawanshi et al. [65] demonstrated a distinctive antiviral effect of prodigiosin, produced by S. marcescens, on herpes simplex virus (HSV) infection. The results indicated that prodigiosin treatment provides a vigorous inhibition of viral duplication in vitro and ex vivo in cultured porcine corneas. Moreover, in ocular infection of murine, prodigiosin initiated protection against HSV-1 infection. For a better description of the inhibition mechanism, prodigiosin effect on NF-κB was scrutinized during infection. Initially, 0.6 μM of prodigiosin was used as a suboptimal dose to study its mechanism in vitro where viral replication is permissible. The results revealed that HSV-1 infection of HCE cells could make a vigorous increase in NF-κB activity and this was confirmed by using an NF-κB-inducible luciferase reporter plasmid. Further examination of factors affecting NF-κB activation, mRNA levels of tumor necrosis factor alpha (TNF-α) were examined. These findings exhibited that TNF-α mRNA levels were downregulated because of the prodigiosin treatment after HSV-1 infection, and this implies that prodigiosin may deliver antiviral activity through inhibition of TNF-α-induced anti-apoptotic mediated activity and prosurvival gene regulation [65].
Conclusion and future perspectives
Positive public opinion regarding natural colors is being encouraged due to the safety and their nontoxic and eco-friendly nature, even with the prevalence of synthetic colorants. Recent researches have revealed that the production of biopigments is an economical approach to extract these beneficial metabolites; however, some limitations still exist including low stability, high cost of downstream processing, technological failures, low yields and toxins production through the process. In this regard, mycotoxin such as citrinin (with orange shade) and other harmful secondary metabolites can be produced at the same time with biopigments and consequently the nontoxic pigments should be distinguished from colored microbial toxins. To meet the growing demand of the global market, development of improved microbial strains and optimization of cultivation parameters are required to obtain a more effective purification method. Moreover, genetic engineering techniques should be investigated to optimize the biopigment production. Considering the recent advances made in the application of agro-industrial waste like lignocellulosic biomass such as nitrogen and carbon sources, the low-cost industrial scale production of biopigments is possible in near future. In addition, new studies have focused on explaining the action mechanism of pharmacological aspects of biopigments, which would be actually useful in discovering novel approaches for the survival of human beings against perilous diseases like cancer. In this way, future surveys should be more directed on the chemical structure of microbial pigments and the association between their structures and pharmacological function.
Availability of data and material
Not applicable.
Code availability
Not applicable.
Change history
15 October 2021
The original version of this article was revised to update the acknowledgements.
15 October 2021
A Correction to this paper has been published: https://doi.org/10.1007/s00449-021-02641-4
References
Abdel Ghany T (2015) Safe food additives. A review. J Biol Chem Res 32(1):402–437
Sánchez-Muñoz S, Mariano-Silva G, Leite MO, Mura FB, Verma ML, da Silva SS et al (2020) Production of fungal and bacterial pigments and their applications. Biotechnol Prod Bioactive Compd 2020:327–361
Venil CK, Zakaria A, Ahmad W (2013) Bacterial pigments and their applications. Process Biochem 48(7):1065–1079
Venil CK, Velmurugan P, Dufossé L, Devi PR, Ravi AV (2020) Fungal Pigments: potential coloring compounds for wide ranging applications in textile dyeing. J Fungi 6(2):68
Shindo K, Misawa N (2014) New and rare carotenoids isolated from marine bacteria and their antioxidant activities. Mar Drugs 12(3):1690–1698
Lagashetti AC, Dufossé L, Singh SK, Singh PN (2019) Fungal pigments and their prospects in different industries. Microorganisms 7(12):604
Dufossé L (2018) Red colourants from filamentous fungi: are they ready for the food industry? J Food Compos Anal 69:156–161
Subhasree R, Babu PD, Vidyalakshmi R, Mohan VC (2011) Effect of carbon and nitrogen sources on stimulation of pigment production by Monascus purpureus on jackfruit seeds. Int J Microbiol Res (IJMR) 2(2):184–187
Petruk, G., M. Roxo, F. De Lise, F. Mensitieri, E. Notomista, M. Wink et al (2019) The marine Gram-negative bacterium Novosphingobium sp PP1Y as a potential source of novel metabolites with antioxidant activity. Biotechnology letters 41(2): 273–281.
Kumar, A., H.S. Vishwakarma, J. Singh, S. Dwivedi, and M. Kumar, Microbial pigments: production and their applications in various industries. International Journal of Pharmaceutical, Chemical & Biological Sciences, 2015. 5(1).
Tarhriz V, Eyvazi S, Shakeri E, Hejazi MS, Dilmaghani A (2020) Antibacterial and antifungal activity of novel freshwater bacterium Tabrizicola aquatica as a prominent natural antibiotic available in Qurugol Lake. Pharmaceut Sci 26(1):88–92
Seyfi R, Kahaki FA, Ebrahimi T, Montazersaheb S, Eyvazi S, Babaeipour V et al (2020) Antimicrobial peptides (AMPs): roles, functions and mechanism of action. Int J Pept Res Ther 26(3):1451–1463
Bhagwat A, Padalia U (2020) Optimization of prodigiosin biosynthesis by Serratia marcescens using unconventional bioresources. J Genet Eng Biotechnol 18(1):1–9
Ahn S-Y, Jang S, Sudheer PD, Choi K-Y (2021) Microbial production of melanin pigments from caffeic acid and L-tyrosine using Streptomyces glaucescens and FCS-ECH-expressing Escherichia coli. Int J Mol Sci 22(5):2413
de Almeida, A.B., N.H. Santos, T.M. de Lima, R.V. Santana, J.G. de Oliveira Filho, D.S. Peres et al, Pigment bioproduction by Monascus purpureus using corn bran, a byproduct of the corn industry. Biocatalysis and Agricultural Biotechnology, 2021. 32: p. 101931.
Bouhri, Y., T. Askun, B. Tunca, G. Deniz, S.A. Aksoy, and M. Mutlu, The orange-red pigment from Penicillium mallochii: Pigment production, optimization, and pigment efficacy against Glioblastoma cell lines. Biocatalysis and Agricultural Biotechnology, 2020. 23: p. 101451.
Yang, Y., N. Bu, S. Wang, J. Zhang, Y. Wang, and C. Dong, Carotenoid Production by Caterpillar Medicinal Mushrooms, Cordyceps militaris (Ascomycetes), under Different Culture Conditions. International Journal of Medicinal Mushrooms, 2020. 22(12).
Kalra R, Conlan XA, Goel M (2020) Fungi as a potential source of pigments: harnessing filamentous fungi. Front Chem 8:369
Khan, A.A., A.M. Alshabi, Y.S. Alqahtani, A.M. Alqahtani, R. Bennur, I.A. Shaikh et al, Extraction and identification of fungal pigment from Penicillium europium using different spectral studies. Journal of King Saud University-Science, 2021. 33(4): p. 101437.
Saini DK, Chakdar H, Pabbi S, Shukla P (2020) Enhancing production of microalgal biopigments through metabolic and genetic engineering. Crit Rev Food Sci Nutr 60(3):391–405
Dufosse L, Fouillaud M, Caro Y, Mapari SA, Sutthiwong N (2014) Filamentous fungi are large-scale producers of pigments and colorants for the food industry. Curr Opin Biotechnol 26:56–61
Nawaz A, Chaudhary R, Shah Z, Dufossé L, Fouillaud M, Mukhtar H (2021) An Overview on Industrial and Medical Applications of Bio-Pigments Synthesized by Marine Bacteria. Microorganisms 9(1):11
Galasso C, Corinaldesi C, Sansone C (2017) Carotenoids from marine organisms: Biological functions and industrial applications. Antioxidants 6(4):96
Varmira K, Habibi A, Moradi S, Bahramian E (2018) Experimental Evaluation of Airlift Photobioreactor for Carotenoid Pigments Production by Rhodotorula rubra. Romanian Biotechnological Letters 23(4):13843
Panesar R, Kaur S, Panesar PS (2015) Production of microbial pigments utilizing agro-industrial waste: a review. Curr Opin Food Sci 1:70–76
de Medeiros, V.P.B., T.C. Pimentel, R.C.R. Varandas, S.A. Dos Santos, G.T. de Souza Pedrosa, C.F. da Costa Sassi et al, Exploiting the use of agro-industrial residues from fruit and vegetables as alternative microalgae culture medium. Food Research International, 2020. 137: p. 109722.
Parmar M, Phutela UG (2015) Biocolors: the new generation additives. Int J Curr Microbiol App Sci 4(7):688–694
Pombeiro-Sponchiado, S.R., G.S. Sousa, J.C. Andrade, H.F. Lisboa, and R.C. Gonçalves, Production of melanin pigment by fungi and its biotechnological applications. Melanin, 2017: p. 47–75.
Liu J, Luo Y, Guo T, Tang C, Chai X, Zhao W et al (2020) Cost-effective pigment production by Monascus purpureus using rice straw hydrolysate as substrate in submerged fermentation. J Biosci Bioeng 129(2):229–236
Loh WLC, Huang K-C, Ng HS, Lan JC-W (2020) Exploring the fermentation characteristics of a newly isolated marine bacteria strain, Gordonia terrae TWRH01 for carotenoids production. J Biosci Bioeng 130(2):187–194
Sanghavi G, Gupta P, Rajput M, Oza T, Trivedi U, Singh NK (2020) Microbial Strain Engineering. Engineering of Microbial Biosynthetic Pathways. Springer, pp 11–32
Sen T, Barrow CJ, Deshmukh SK (2019) Microbial pigments in the food industry–challenges and the way forward. Front Nutr 6:7
Venil, C.K., L. Dufossé, and P. Renuka Devi, Bacterial pigments: sustainable compounds with market potential for pharma and food industry. Frontiers in Sustainable Food Systems, 2020. 4: p. 100.
Liu J, Du Y, Ma H, Pei X, Li M (2020) Enhancement of Monascus yellow pigments production by activating the cAMP signalling pathway in Monascus purpureus HJ11. Microb Cell Fact 19(1):1–11
Song I, Kim J, Baek K, Choi Y, Shin B, Jin E (2020) The generation of metabolic changes for the production of high-purity zeaxanthin mediated by CRISPR-Cas9 in Chlamydomonas reinhardtii. Microb Cell Fact 19(1):1–9
Campos DA, Gómez-García R, Vilas-Boas AA, Madureira AR, Pintado MM (2020) Management of fruit industrial by-products–A case study on circular economy approach. Molecules 25(2):320
Nevzglyadova O, Mikhailova E, Artemov A, Ozerova Y, Ivanova P, Golomidov I et al (2018) Yeast red pigment modifies cloned human α-synuclein pathogenesis in Parkinson disease models in Saccharomyces cerevisiae and Drosophila melanogaster. Neurochem Int 120:172–181
Fernandes, A.S., T.C. do Nascimento, E. Jacob-Lopes, V.V. De Rosso, and L.Q. Zepka, Carotenoids: A brief overview on its structure, biosynthesis, synthesis, and applications. Progress in carotenoid research, 2018: p. 1–15.
Seel W, Baust D, Sons D, Albers M, Etzbach L, Fuss J et al (2020) Carotenoids are used as regulators for membrane fluidity by Staphylococcus xylosus. Sci Rep 10(1):1–12
Rapoport A, Guzhova I, Bernetti L, Buzzini P, Kieliszek M, Kot AM (2021) Carotenoids and Some Other Pigments from Fungi and Yeasts. Metabolites 11(2):92
Mussagy CU, Winterburn J, Santos-Ebinuma VC, Pereira JFB (2019) Production and extraction of carotenoids produced by microorganisms. Appl Microbiol Biotechnol 103(3):1095–1114
Lobo PTD, Brandão HN, Assis SA (2021) Production of carotenoids by Rhodotorula mucilaginosa using sugarcane juice (Saccharum officinarum) in the fermentation. Brazilian Journal of Development 7(2):18235–18250
Rana B, Bhattacharyya M, Patni B, Arya M, Joshi GK (2021) The Realm of Microbial Pigments in the Food Color Market. Frontiers in Sustainable Food Systems 5:54
Corradini, M.G., Synthetic food colors. Encyclopedia of Food Chemistry, 2019: p. 291–296.
Nigam PS, Luke JS (2016) Food additives: production of microbial pigments and their antioxidant properties. Curr Opin Food Sci 7:93–100
da Costa Cardoso, L.A., K.Y.F. Kanno, and S.G. Karp, Microbial production of carotenoids A review. African journal of Biotechnology, 2017. 16(4): p. 139–146.
Hamilton GE, Luechau F, Burton SC, Lyddiatt A (2000) Development of a mixed mode adsorption process for the direct product sequestration of an extracellular protease from microbial batch cultures. J Biotechnol 79(2):103–115
Zhu, Y., X. Shang, L. Yang, S. Zheng, K. Liu, and X. Li, Purification, identification and properties of a new blue pigment produced from Streptomyces sp. A1013Y. Food chemistry, 2020. 308: p. 125600.
de Mejia EG, Zhang Q, Penta K, Eroglu A, Lila MA (2020) The colors of health: Chemistry, bioactivity, and market demand for colorful foods and natural food sources of colorants. Annu Rev Food Sci Technol 11:145–182
Usman H, Abdulkadir N, Gani M, Maiturare H (2017) Bacterial pigments and its significance. MOJ Bioequiv Availab 4(3):00073
Dufossé L (2006) Microbial production of food grade pigments. Food Technology and Biotechnology 44(3):313–323
Saleem, H., S. Mazhar, Q. Syed, M.Q. Javed, and A. Adnan, Bio-characterization of food grade pyocyanin bio-pigment extracted from chromogenic Pseudomonas species found in Pakistani native flora. Arabian Journal of Chemistry, 2021. 14(3): p. 103005.
Ramesh, C., N.V. Vinithkumar, R. Kirubagaran, C.K. Venil, and L. Dufossé, Applications of Prodigiosin Extracted from Marine Red Pigmented Bacteria Zooshikella sp. and Actinomycete Streptomyces sp. Microorganisms, 2020. 8(4): p. 556.
Derikvand, P., C.A. Llewellyn, and S. Purton, Cyanobacterial metabolites as a source of sunscreens and moisturizers: a comparison with current synthetic compounds. European Journal of Phycology, 2017. 52(1): p: 43–56.
Srinivasan, M., S.M. Keziah, M. Hemalatha, and C.S. Devi. Pigment from Streptomyces bellus MSA1 isolated from marine sediments. in IOP Conference Series: Materials Science and Engineering. 2017. IOP Publishing.
El-Naggar, N.E.-A. and S.M. El-Ewasy, Bioproduction, characterization, anticancer and antioxidant activities of extracellular melanin pigment produced by newly isolated microbial cell factories Streptomyces glaucescens NEAE-H. Scientific reports, 2017. 7(1): p: 1–19.
Choksi J, Vora J, Shrivastava N (2020) Bioactive Pigments from Isolated Bacteria and Its Antibacterial, Antioxidant and Sun Protective Application Useful for Cosmetic Products. Indian Journal of Microbiology 60(3):379–382
Azman, A.-S., C.-I. Mawang, and S. Abubakar, Bacterial pigments: the bioactivities and as an alternative for therapeutic applications. Natural Product Communications, 2018. 13(12): p. 1934578X1801301240.
Keekan KK, Hallur S, Modi PK, Shastry RP (2020) Antioxidant activity and role of culture condition in the optimization of red pigment production by Talaromyces purpureogenus KKP through response surface methodology. Curr Microbiol 77(8):1780–1789
Zeng, H., L. Qin, X. Liu, and S. Miao, Increases of Lipophilic Antioxidants and Anticancer Activity of Coix Seed Fermented by Monascus purpureus. Foods, 2021. 10(3): p: 566.
Peller M, Katalinic A, Wollenberg B, Teudt IU, Meyer J-E (2016) Epidemiology of laryngeal carcinoma in Germany, 1998–2011. Eur Arch Otorhinolaryngol 273(6):1481–1487
Alem D, Marizcurrena JJ, Saravia V, Davyt D, Martinez-Lopez W, Castro-Sowinski S (2020) Production and antiproliferative effect of violacein, a purple pigment produced by an Antarctic bacterial isolate. World J Microbiol Biotechnol 36(8):1–11
Dawoud TM, Alharbi NS, Theruvinthalakal AM, Thekkangil A, Kadaikunnan S, Khaled JM et al (2020) Characterization and antifungal activity of the yellow pigment produced by a Bacillus sp. DBS4 isolated from the lichen Dirinaria agealita. Saudi J Biol Sci 27(5):1403–1411
Pachaiyappan A, Sadhasivam G, Kumar M, Muthuvel A (2020) Biomedical potential of astaxanthin from novel endophytic pigment producing bacteria Pontibacter korlensis AG6. Waste Biomass Valoriz 2020:1–11
Suryawanshi RK, Koujah L, Patil CD, Ames JM, Agelidis A, Yadavalli T et al (2020) Bacterial pigment prodigiosin demonstrates a unique antiherpesvirus activity that is mediated through inhibition of prosurvival signal transducers. J Virol 94(13):e00251
Shetty AVK, Dave N, Murugesan G, Pai S, Pugazhendhi A, Varadavenkatesan T et al (2021) Production and extraction of red pigment by solid-state fermentation of broken rice using Monascus sanguineus NFCCI 2453. Biocatal Agric Biotechnol 2021:101964
Garcia-Cortes A, Garcia-Vásquez JA, Aranguren Y, Ramirez-Castrillon M (2021) Pigment production improvement in Rhodotorula mucilaginosa AJB01 using design of experiments. Microorganisms 9(2):387
Poddar K, Padhan B, Sarkar D, Sarkar A (2021) Purification and optimization of pink pigment produced by newly isolated bacterial strain Enterobacter sp. PWN1. SN Appl Sci 3(1):1–11
Arikan EB, Canli O, Caro Y, Dufossé L, Dizge N (2020) Production of bio-based pigments from food processing industry by-products (apple, pomegranate, black carrot, red beet pulps) using Aspergillus carbonarius. J Fungi 6(4):240
Mahmoud GA-E, Soltan HA, Abdel-Aleem WM, Osman SA (2020) Safe natural bio-pigment production by Monascus purpureus using mixed carbon sources with cytotoxicity evaluation on root tips of Allium cepa L. J Food Sci Technol 2020:1–12
Menezes BS, Solidade LS, Conceição AA, Junior MNS, Leal PL, de Brito ES et al (2020) Pigment production by Fusarium solani BRM054066 and determination of antioxidant and anti-inflammatory properties. AMB Express 10(1):1–12
Darwesh OM, Matter IA, Almoallim HS, Alharbi SA, Oh Y-K (2020) Isolation and optimization of Monascus ruber OMNRC45 for red pigment production and evaluation of the pigment as a food colorant. Appl Sci 10(24):8867
Venkatachalam M, Shum-Chéong-Sing A, Dufossé L, Fouillaud M (2020) Statistical optimization of the physico-chemical parameters for pigment production in submerged fermentation of Talaromyces albobiverticillius 30548. Microorganisms 8(5):711
Keivani H, Jahadi M, Ghasemisepero N (2020) Optimizing submerged cultivation for the production of red pigments by Monascus purpureus on soybean meals using response surface methodology. Appl Food Biotechnol 7(3):143–152
Caro Y, Anamale L, Fouillaud M, Laurent P, Petit T, Dufossé L (2012) Natural hydroxyanthraquinoid pigments as potent food grade colorants: an overview. Nat Prod Bioprospect 2(5):174–193
Aruldass CA, Masalamany SRL, Venil CK, Ahmad WA (2018) Antibacterial mode of action of violacein from Chromobacterium violaceum UTM5 against Staphylococcus aureus and methicillin-resistant Staphylococcus aureus (MRSA). Environ Sci Pollut Res 25(6):5164–5180
Manimaran M, Rajkumar T, Vimal S, Taju G, Majeed SA, Hameed AS et al (2018) Antiviral activity of 9 (10H)-Acridanone extracted from marine Streptomyces fradiae strain VITMK2 in Litopenaeus vannamei infected with white spot syndrome virus. Aquaculture 488:66–73
Barretto DA, Vootla SK (2018) In Vitro anticancer activity of staphyloxanthin pigment extracted from Staphylococcus gallinarum KX912244, a gut microbe of Bombyx mori. Indian J Microbiol 58(2):146–158
Gjadhar S, Mellem JJ (2019) Isolation and characterization of a microbial pigment obtained from Serratia marcescens as a natural food colourant. Ann Univ Dunarea de Jos of Galati Fascicle VI Food Technol 43(1):137–154
Sharma R, Ghoshal G (2020) Optimization of carotenoids production by Rhodotorula mucilaginosa (MTCC-1403) using agro-industrial waste in bioreactor: a statistical approach. Biotechnology Reports 25:e00407
Harith ZT, de Andrade Lima M, Charalampopoulos D, Chatzifragkou A (2020) Optimised production and extraction of astaxanthin from the yeast Xanthophyllomyces dendrorhous. Microorganisms 8(3):430
Majumdar S, Mandal T, Mandal DD (2020) Production kinetics of β-carotene from Planococcus sp. TRC1 with concomitant bioconversion of industrial solid waste into crystalline cellulose rich biomass. Process Biochem 92:202–213
Pang L, Antonisamy P, Esmail GA, Alzeer AF, Al-Dhabi NA, Arasu MV et al (2020) Nephroprotective effect of pigmented violacein isolated from Chromobacterium violaceum in wistar rats. Saudi journal of biological sciences 27(12):3307–3312
Mal SA, Ibrahim GS, Maha I, Khalaf Al, Al-Hejin AM, Bataweel NM et al (2020) Production and partial characterization of yellow pigment produced by Kocuria Flava isolate and testing its antioxidant and antimicrobial activity. Int J Life Sci Pharma Res 10(2):58–66
Sengupta S, Bhowal J (2021) Study on the antioxidant and cytotoxic properties of Pyocyanin extracted from Pseudomonas aeruginosa. Advances in Bioprocess Engineering and Technology. Springer, pp 133–141
Acknowledgements
This study is related to the project no. 1398/9812 from Student Research Committee, Shahid Beheshti University of Medical Sciences, Tehran, Iran. We also appreciate the “Student Research Committee” and “Research & Technology Chancellor” in Shahid Beheshti University of Medical Sciences for their financial support of this work. Laurent Dufossé deeply thanks the Conseil Régional de La Réunion, Indian Ocean, for continuous financial support of research projects dedicated to microbial pigments and shows gratitude to Mireille Fouillaud and Yanis Caro for many years of close association in microbial pigments research
Funding
This study is related to the project NO. 1398/9812 from Student Research Committee, Shahid Beheshti University of Medical Sciences, Tehran, Iran.
Author information
Authors and Affiliations
Contributions
MAM had the idea for the article, MAM and HA performed the literature search and data analysis, MAM, HA and SM drafted and critically revised the work. SMH and LD reviewed the manuscript and provided technical assistance to keep the manuscript on track.
Corresponding authors
Ethics declarations
Conflict of interest
The authors state that they have no conflicts of interest to declare.
Additional information
Publisher's Note
Springer Nature remains neutral with regard to jurisdictional claims in published maps and institutional affiliations.
The original version of this article was revised to update the acknowledgements.
Rights and permissions
About this article
Cite this article
Aman Mohammadi, M., Ahangari, H., Mousazadeh, S. et al. Microbial pigments as an alternative to synthetic dyes and food additives: a brief review of recent studies. Bioprocess Biosyst Eng 45, 1–12 (2022). https://doi.org/10.1007/s00449-021-02621-8
Received:
Accepted:
Published:
Issue Date:
DOI: https://doi.org/10.1007/s00449-021-02621-8